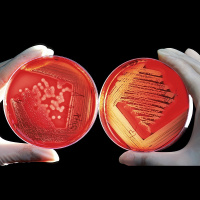
Ķīmisko vielu biomonitorings

Sinopsis
Populrzintnisks radiournls, kas aptver dadas zintnes nozares, izzina dabu, ekoloiju, eogrfiju, ornitoloiju, zooloiju, astronomiju, arheoloiju, vsturi, ielkojas zintnes un tehnikas sasniegumos, izcilu personbu dzv un darbb. paa uzmanba veltta latvieu zintnieku sasniegumiem pasaul un Latvij.aj informatvi izgltojoaj programm paredztas regulras rubrikas, piemram, interesanto un aktulo faktu mintes, Dienas jautjums klaustjiem, Ikona jeb ss ieskats kdas pardbas vai lietas izcelsm un vstur, k ar ststjums par noslpumainm un maz izzintm norism dab.Katr raidjum kop ar ptniekiem iztirzjam galveno tematu, uz sadarbbu aicinot ar savus klaustjus, vai k citdi uzklausot cilvku viedokus un jautjumus.
Episodios
-
Zaļā stiklene un skrejvaboļu milnene - šogad interesanti atradumi sēņu pasaulē
17/09/2025 Duración: 48minŠogad interesanti atradumi sēņu pasaulē, tostarp šī gada sēne - zaļā stiklene un skrejvaboļu milnene - sēne, kas parazitē uz kukaiņiem. Kāda ir sēņu daudzveidība šogad mežos un kā parazītsēnes pakļauj sev dažādus kukaiņus? Raidījumā Zināmais nezināmajā stāsta Latvijas Nacionālā dabas muzeja mikoloģe Diāna Meiere un Latvijas Nacionālā dabas muzeja entomologs Uģis Piterāns. Indīgo dzīvnieku pasaule: mazākie ir niknākie Inde dzīvniekiem kalpo diviem mērķiem: lai sagādātu sev barību un lai aizsargātos no uzbrucējiem. Lieki neviens dzīvnieks ar savu indi nešķaidās, ja nu vienīgi spļāvējkobra, kas sastopama Āfrikā un Āzijā un kas aizsargājoties mēdz izspļaut indi pat trīs metru attālumā. Ja šī inde nonāk upurim acīs un laikus apspļautajam nesniedz medicīnisko palīdzību, tas var izraisīt aklumu. Runājot par indīgajiem dzīvniekiem, pirmais, kas nāk prātā ir čūskas, taču tikai ceturtā daļa no visām pasaulē mītošajām čūsku sugām ir indīgas, tai skaitā vienīgā Latvijā dzīvojošā indes nēsātāja – odze. Bet, kā teic Rī
-
Mūsdienās putnu pētniekiem talkā nāk arī tehnoloģijas. Viena no metodēm ir telemetrija
16/09/2025 Duración: 23minIr putni, par kuru klātbūtni mums nav jāuztraucas, tie diendienā sastopami mums līdzāstaču ir sugas, kuras izvairās no cilvēka un to populācija ir tik ļoti sarukusi, ka nepieciešami visi iespējamie līdzekļi, lai tos pasargātu. Ornitologi datus par putniem ierasti ievāc, dodoties dabā, kur pēc putnu balsīm u.c. pazīmēm jāspēj noteikt sugas un to izplatība konkrētā vietā. Taču mūsdienās putnu pētniekiem talkā nāk arī tehnoloģijas, kas ļauj putnus novērot un uzskaitīt arī attālināti, viena no metodēm ir telemetrija. Kā tā palīdz ūpju izpētē un ne tikai, raidījumā Zināmais nezināmajā skaidro ornitologs Latvijas Ornitoloģijas biedrības Ūpju programmas vadītājs Pēteris Daknis un Latvijas Ornitoloģijas biedrības sabiedrības izglītošanas un iesaistes virziena vadītājs Agnis Bušs.
-
Laikapstākļu, klimata un augsnes savstarpēja mijiedarbe
16/09/2025 Duración: 23minŠoreiz klausītāju rosināts temats par to, kā laikapstākļi un klimats ietekmē augsni. Jeb konkrētāk, kā mainās ūdens jeb hidroloģiskais režīms augsnē, piemēram, pēc meža nociršanas, kad augsne ir traktoru izbraukāta un sadragāti augi un visa veģetācijas sega. Pēc sarunas ar diviem jomas speciālistiem izkristalizējās divi galvenie virzieni, kā laikapstākļi, klimats un augsne mijiedarbojas gada siltā daļā, kad augsnei ir būtiska loma ūdens gan novadīšanā, gan arī sausuma periodā tā saglabāšanā, kā aukstajā periodā – ziemā, kad notiek augsnes sasalšana. Tas savukārt būtiski ietekmē būves un šajā sadaļā Latvijā jau ir labi novērojama klimata pārmaiņu ietekme. Vasarā bieži ir problēmas ar sausumu un zemē, kas saulē pārkaltusi, ūdens neuzsūcas. To droši vien ir pamanījuši visi, kas darbojas dārzā, pietiek pat ar puķu podiem istabā – ja tā kārtīgi iekaltē, grūti pēc tam augsni samitrināt. Kāpēc tā notiek, skaidro ģeoloģijas doktors, Latvijas Universitātes Ģeoloģisko procesu izpētes un modelēšanas centra vadītājs An
-
Astrofotogrāfija jeb kā top skaistas un zinātniskas kosmosa fotogrāfijas
15/09/2025 Duración: 49minAstrofotogrāfija ir īpaša fotogrāfijas joma, tā ļauj ne tikai saskatīt to, ko mūsu acis nakts tumsā nespēj, bet arī sniedz daudz zinātnisku datu par objektiem un norisēm tālu aiz apvāršņa. Kā top skaistas un zinātniskas kosmosa fotogrāfijas? Ko var izdarīt neprofesionālis un kā top profesionālu astronomu attēli? Par to raidījumā Zināmais nezināmajā stāsta astrofotogrāfi Jānis Šatrovskis un Raimons Elsbergs un "Starspace" observatorijas saimniece Anna Gintere. Mēness poētiskie nosaukumi un arī vārda pareizrakstība Mēness ir tas debess spīdeklis, kura izmaiņas izmēros un krāsu toņos dažādām tautām laika gaitā devušas ierosmi piešķirt spīdeklim interesantus apzīmējumus. Cilvēki bieži vien sarosās, kad uzzina par drīzumā gaidāmu “asiņaino Mēnesi” vai “Zemeņu pilnmēnesi”, un arī mēs par šīm norisēm esam vēstījuši raidījuma zinātnes ziņu izlaidumos. Vai astronomiem bieži iznāk saskarties ar kādiem debess ķermeņu poētiskiem nosaukumiem? To vaicāju Latvijas Universitātes astronomam Ilgonim Vilkam. Viņš norāda, ka t
-
Šķirstām "Latvijas arheoloģijas rokasgrāmatu", kas tagad izdota arī angļu valodā
11/09/2025 Duración: 46minLatvijas arheologu kopdarbam - 700 lappušu biezajai un gandrīz četrus kilogramus smagajai "Latvijas arheoloģijas rokasgrāmatai" nule tapis izdevums angļu valodā. Šķirstām grāmatu kopā ar pieredzējušiem arheologiem un skaidrojam aizraujošākos Latvijas vēstures atklājumus. Raidījumā Zināmais nezināmajā sarunājas antropoloģe, Latvijas vēstures institūta vadošā pētniece Gunita Zariņa, vēsturnieks un arheologs Juris Tālivaldis Urtāns, arheoloģe, vēstures zinātņu doktore Antonija Vilcāne un vēsturnieks, arheologs, Latvijas Universitātes profesors Andrejs Vasks. Raidījuma noslēgumā zinātnes ziņas. Nacionālās aeronautikas un kosmosa administrācijas jeb NASA pašgājējs robots “Neatlaidība” (Perseverance) guvis līdz šim labāko pierādījumu dzīvībai uz Marsa. Bet kāds cits pētījums atklāj, ka cilvēka cilmes šūnas kosmosā nolietojas un noveco daudz ātrāk, un tā varētu būt problēma ikvienam, kurš cer doties garā ceļojumā pa mūsu Saules sistēmu. No atšķirīgiem skatpunktiem zinātnes jaunumu vietnēs aprakstīti kaņepju ri
-
Zaļā enerģija ienāk arī jūras transportā
10/09/2025 Duración: 47minLatvijā top pirmais piekrastes zvejas kuģis, kuru darbinātu elektrība un ūdeņradis. Līdz šim jūras transportā zaļā enerģija nav plaši izmantota, bet, ņemot vērā piesārņojumu un emisijas, ko pasaulē rada kuģu kustība, inovācijas ir nepieciešamas. Par to, kā kursētu šāds kuģis un vai nākotnē varam cerēt, ka arī pasažieru un kravas kuģi kļūs videi un klimatam draudzīgāki, saruna raidījumā Zināmais nezināmajā. Stāsta Rīgas Tehniskās universitātes vadošo pētnieku Andrejs Zvaigzne un Vidzemes Augstskolas Sociotehnisku sistēmu inženierijas institūta direktors, vadošais pētnieks Oskars Java. Slavenākie kuģi Latvijas vēsturē Galvenais jeb flagmaņkuģis „Virsaitis”, dmīnu meklētāji „Imanta” un „Viesturs” un zemūdenes „Ronis” un „Spīdola”. Domāju, šos vārdus ir dzirdējuši daudzi, ja runājam par starpkaru Latvijas Republikas Jūras kara floti. Skaitā neliela, bet tam laikam moderna, kaujās šie peldlīdzekļi nepiedalījās, bet liela nozīme tiem bija krasta aizsardzībā un mūsu jūrnieku apmācības procesā. Mūsu kara
-
Polārpētniekiem svarīgās polārās stacijas: to izveide ir arī politisks jautājums
09/09/2025 Duración: 27minCivilizācijas, komforta un drošības saliņa polārajos reģionos un tālos ledājos - stacijas. Tajās notiek ne tikai pētnieku ikdienas sadzīve, bet arī pētniecība. Kāda ir polārstaciju loma zinātnē, kādu ir dzīve stacijās un kādiem apstākļiem tās ir pakļautas? Un kāpēc polāro staciju izveide ir arī politisks jautājums? Par mūsu polārpētnieku piedzīvojumiem un pētniecību dažādos pasaules ledājos esam stāstījuši daudz un ar aizrautību sekojuši līdzi viņu ekspedīcijām, taču tikai garāmejot esam pieminējuši kādu civilizācijas saliņu polārajos apgabalos un tās ir polārās stacijas. Par šīm mītnes vietām ledājos, to politisko, sociālo un pētniecības nozīmi saruna raidījumā Zināmais nezināmajā. Studijā polārpētnieki - Jānis Karušs, Latvijas Universitātes Eksakto zinātņu un tehnoloģiju fakultātes asociētie profesors, un Kristaps Lamsters, Latvijas Universitātes Eksakto zinātņu un tehnoloģiju fakultātes asociētie profesors.
-
Latvijā būs vairāk meteoroloģisko novērojumu staciju
09/09/2025 Duración: 22minLatvijas Vides, ģeoloģijas un meteoroloģijas centrs plāno paplašināt meteostaciju tīklu. Īpaši gaidīts notikums ir jauna meteoroloģiskā radara uzstādīšana Rīgas lidostā, kur šobrīd ir tikpat kā nefunkcionējošs vecais. Vēl vienu jaunu radaru plānots uzstādīt Kuldīgā. Latvijā šobrīd darbojas 25 meteoroloģiskās stacijas, kas mēra ļoti plašu meteoroloģisko elementu klāstu. Tā ir temperatūra, gaisa mitrums, vēja ātrums, atmosfēras spiediens, nokrišņu veids, daudzums un intensitāte, sniega segas biezums, atmosfēras spiediens. Dažās meteostacijās ar speciālu lāzerstaru veic arī mākoņu novērojumus un fiksē saules spīdēšanas ilgumu, meteostacijā Rucavā veic arī ultravioletā starojuma intensitātes novērojumus. Vēl bez šīm 25 meteostacijām ir septiņas papildstacijas, kurās ir neliels mērījumu klāsts, pamatā nokrišņus un sniega segas biezumu tur mēra. Plānā ir desmit jaunu meteoroloģisko staciju izveide, tās būs Ventspils novada Ugālē, Dienvidkurzemes novada Kalvenē, Tukuma novada Irlavā, viena jauna meteostacija arī
-
Komandas darbs - skudru, cilvēku un robotu kolektīvā
08/09/2025 Duración: 48minNesen kāds pētījums atklājis interesantu faktu par skudru spēju darboties komandā - kad pūznī strauj aug iemītnieku skaits, skudras strādā smagāk un vairāk kopējā pūžņa labuma vārdā. Cilvēku sabiedrībā mēs nereti novērojam pretējo, ka lielākos kolektīvos mūsu uzņēmība un motivācija ziedoties sarūk. Vienlaikus skudru stratēģijas pārņemšana varētu palīdzēt risināt grūtības robotu "kolektīvā". Kā mainās cilvēku, skudru un robotu uzvedība, kad jāsāk darboties komandā? Ko cilvēki un roboti varētu mācīties no dzīvnieku pasaules komandas saliedēšanā un cik labi komandas spēlētāji ir cilvēki un viņu radītās ierīces? Raidījumā Zināmais nezināmajā analizē Ivars Austers, Latvijas Universitātes profesors sociālajā psiholoģijā, Jānis Dreimanis, Latvijas Dabas muzeja entomologs, un Agris Ņikitenko, Rīgas Tehniskās universitātes Datorzinātnes, informācijas tehnoloģijas un enerģētikas fakultātes dekāns, profesors.
-
Vulkānu un zemestrīču pētniecība pasaulē un Latvijā
04/09/2025 Duración: 46minLatvija atrodas seismiski neaktīvā zonā, tomēr arī te notiek pazemes kustību pētījumi un arī mūs ietekmē procesi, kas klusām ris zem mūsu kājām? Kas īsti ir seismologa pētījumu lauks? Kā vulkānus un zemestrīces pēta pasaulē un Latvijā? Tiekamies sarunā ar Latvijas pirmo un pagaidām vienīgo seismologu - Latvijas Universitātes Ģeogrāfijas un zemes zinātņu fakultātes pētnieku Viesturu Zandersonu. Seismoloģija ir fascinējoša ģeoloģijas apakšnozare, kas pēta mūsu planētas plātņu kustības un to radītās izpausmes. Par vulkāniem un zemestrīcēm tuvu un tālu no Latvijas; par to, kādi riski mums varētu draudēt, ja izvirstu kāds vulkāns tuvu Eiropā un kā vispār pēta šādus procesus, saruna raidījumā. Uzklausām arī Gunu Kalnu-Kjartansoni, gidi, kura komentē civilo aizsardzību seismiski aktīvās zonās.
-
Plastmasas daudzums pieaug: "slīkt plastmasā" vairs nav tikai tēlains izteiciens
03/09/2025 Duración: 48minAugustā noslēgusies kārtējā "Mana jūra" ekspedīcija Latvijā, bet Ženēvā nesekmīgi beigušās sarunas par plastmasas lietojumu un piesārņojumu pasaulē. Kāda šobrīd situācija ar plastmasas ražošanu un pārstrādi pasaulē un ko pētījumi stāsta par plastmasas ceļu dabā? Raidījumā Zināmais nezināmajā analizē Jānis Ulme, Vides izglītības fonda pārstāvis, Jānis Brizga, Latvijas Universitātes pētnieks, biedrības "Zaļā brīvība" pārstāvis, un Inta Dimante-Deimantoviča, Latvijas Hidroekoloģijas institūta vadošā pētniece un mikroplastmasas laboratorijas vadītāja. "Mikroplastmasa ir plastmasas piesārņojuma nākotne," atzīst Inta Dimante-Deimantoviča. "Globāli raugoties, plastmasas atkritumi, nonākot vidē, tos ietekmē saules gaismā, dažādi citi apstākļi, kā rezultātā plastmasa kā materiāls sadalās aizvien mazākās daļiņās un uzkrājas vidē mikroplastmasas veidā. Un mikroplastmasas veidā arī kļūst ļoti mobila, jo tiek aizpūsta ar vēju, aiznesta nokrišņiem, tiek apēsta, pēc tam izdalīta un atkal apēsta. Viss tas, kas no lielā plas
-
Klimata pārmaiņas ietekmē arī zivju dzīvi un daudzveidību Latvijas ūdeņos
02/09/2025 Duración: 21minLatvijas Biozinātņu un tehnoloģiju universitāte (LBTU) kopā ar zinātnisko institūtu BIOR un citiem sadarbības partneriem izpētījuši galvenos riskus lauksaimniecībā un zivsaimniecībā, klimatam mainoties. Nesen raidījumā stāstījām par pētījumu, kurā skaidrotas klimata pārmaiņu ietekmes jomas lauksaimniecībā. Taču Latvijā darbojamies ne tikai ar sauszemes resursiem, arī zivis ir mūsu dabas bagātība, un arī tās ietekmē klimata izmaiņas. Vai nākotnē mainīsies zivju sabiedrība mūsu iekšzemes ūdeņos un jūrā un ko tas nozīmē zivsaimniecībai? Vai zivis kļūs mazākas, retākas, sugu ziņā vienveidīgākas un kā mainīsies to nārstošanas un citi dzīves paradumi? Analizē Pārtikas drošības, dzīvnieku veselības un vides zinātniskā institūta BIOR zivju resursu pētniecības departamenta vadošais pētnieks Ēriks Krūze un biologs, Latvijas Universitātes docents Matīss Žagars.
-
Aizvadīta salīdzinoši vēsā vasara: 20.gs.vidū šī būtu bijusi silta vasara
02/09/2025 Duración: 25minNo pēdējām 102 vasarām, par kurām Latvijas Vides, ģeoloģijas un meteoroloģijas centram ir temperatūras dati, šī vasara ieņem dalīto 30.-32. vietu siltāko vasaru topā. Tātad pēdējo 102 gadu laikā 29 vasaras ir bijušas siltākas par aizvadīto un 70 - vēsākas. Aizvadītās vasaras vidējā temperatūra Latvijā bija 16,5 grādi, kas ir tikai 0,2 grādus vēsāks par klimatisko normu. Turklāt rudens, lai arī atnācis uz palikšanu, meteoroloģiski tas ir iestājies tikai Vidzemes augstienē un austrumos. Citviet turpinās meteoroloģiskā vasara. Klimatiskā norma ir ANO Pasaules meteoroloģijas organizācijas ieviests termins, un ar to apzīmē iepriekšējās trīsdesmitgades vidējos rādītājus. Šobrīd vasaras vidējās temperatūras klimatiskā norma ir tā temperatūra, kāda vidēji bijusi no 1991. līdz 2020. gadam. Klimatiskā norma ir pašu laikapstākļu noteikta. 30 gadu laika posms mērījumiem izraudzīts, jo 30 gadu laikā iekļaujas ja ne visi, tad vairums arī ekstrēmu apstākļu, piemēram, ir kāda ļoti karsta, ir kāda ļoti vēsa, kāda ārkārtī
-
Antropologi turpina mērīt Latvijas iedzīvotājus. Šogad aizvadīta ekspedīcija Kurzemē
01/09/2025 Duración: 47min2024. gadā Rīgas Stradiņa universitātes pētnieki aizsāka ekspedīcijas, kuru pirmsākumi meklējami mērnieku laikos - iedzīvotāju antropoloģisko mērīšanu. Pagājušajā vasarā tā bija Piebalga, šogad lauka pētījumi turpinās Kurzemē. Kādus mūsdienu iedzīvotāju veselības, ķermeņa uzbūves un demogrāfiskos rādītājus pētnieki ieguvuši? Kā esam mainījušies vēstures gaitā? Raidījumā Zināmais nezināmajā skaidro Arta Grabčika, Rīgas Stradiņa universitātes Anatomijas un antropoloģijas institūta asistente, projekta administratore, un Jānis Vētra, Rīgas Stradiņa Universitātes profesors, Anatomijas laboratorijas vadošais pētnieks. "Šajā gadā mēs izvēlējāmies mērījumus veikt trīs pilsētās. Tā varbūt ir tāda būtiska atšķirība no 30. gadiem, kad pārsvarā bija izvēlēti lauku ciemati vai pat viensētas daudzos gadījumos. Mēs izvēlējāmies Kuldīgu, Liepāju un Ventspili," skaidro Jānis Vētra. "Atsaucība bija negaidīti liela. Pētījums katrā pilsētā ilga nepilnas piecas dienas no trešdienas līdz svētdienai, Kuldīgā mums bija 423, Liepājā
-
Izglītība, zināšanas un cilvēka prāts. Vai tiešām kļūstam gudrāki?
28/08/2025 Duración: 51minTehnoloģiju laikmets ļauj klikšķa attālumā piekļūt informācijai par teju visu un zināšanas par pasauli pieejamas sēžot dīvānā. Nav vairs tie laiki, kad ceļš uz izglītību vairumam tika liegts vai šķēršļiem klāts. Un tomēr – vai mēs tiešām kļūstam gudrāki? Vai zināšanas šodien ir vērtīga prece un kā tas bija senāk? Vai mūsu prātam ir robeža, cik daudz informācijas tas spēj uztvert un vai mūsdienu cilvēks zina, ko ar šo bagātību iesākt? Šos tematus šķetināsim sarunā ar Latvijas Universitātes Izglītības zinātņu un psiholoģijas fakultātes profesori Zandu Rubeni, vēsturnieku, Vidzemes Augstskolas padomes locekli un vadošo pētnieku Gati Krūmiņu un Latvijas Universitātes Uztveres un kognitīvo sistēmu laboratorijas vadītāju, profesoru Jurģi Šķilteru.
-
Kāpēc purvam vajag ūdeni? Pabeigta izpēte un sākta atjaunošana Latvijas purvos
27/08/2025 Duración: 46minDabas aizsardzības pārvalde kopā ar Latvijas Valsts mežiem strādā pie purvu ekosistēmas atjaunošanas īpaši aizsargājamās dabas teritorijās. Noslēgušies pirmie darbi, pabeigta izpēte piecos purvos, kur savulaik notikusi kūdras ieguve. Kā stabilizēt ekosistēmu šādā vidē un kāpēc purvam vajag ūdeni? Sarunā piedalās Dabas aizsardzības parvaldes projektu vadītāja Inga Hoņavko, Latvijas Universitātes vadošais pētnieks, ģeologs Andis Kalvāns un botāniķe Agnese Priede. Purvi kalpojuši kā slazds vai kā patvērums arī kaujiniekiem. Šī gada martā traģiskais notikums Lietuvā, kad Pabrades poligonā purvā militāro mācību laikā noslīka ASV armijas bruņumašīna ar četriem kareivjiem iekšā, pirms gadsimta ceturkšņa uzietie padomju armijas tanki purvā pie Pienavas, latviešu strēlnieku kaujas ar vācu armijas vienībām Tīreļpurvā Pirmā pasaules kara laikā un partizānu slēptuves purvos tūlīt pēc Otrā pasaules kara – šie ir tikai daži no piemēriem. Taču tik liela sasaiste šīm vietām ar militāro vēsturi vis nav, saka Nacionālās aizs
-
Veseliem kokiem un veselīgam mežam lietainā vasara kopumā esot ar pluszīmi
26/08/2025 Duración: 23minDažviet Latvijā jau piedzīvotas šogad pirmās rudens salnas, tūliņ klāt arī septembris, tāpēc šķiet, ka jau var izdarīt pirmos secinājumus par to, kā šī neparasti slapjā vasara ir ietekmējusi dzīvo dabu. Toms Bricis interesējies, kādu iespaidu uz kokiem un mežiem atstājis lielais ūdens daudzums. Mežzinātnes institūta "Silava" pētnieki šobrīd ievāc ziņas par tām vietām, kur slapjuma dēļ koki izrāda kādas nīkuļošanas pazīmes, ievāks materiālus un datus un šo neparasti slapjo un vēso vasaru izmantos, lai pētītu, kādi tad ir tie apstākļi, kuros koks jau vairs nejūtas labi, kādi koki ātrāk sāk paust nepatiku pret šādu vasaru un kādas tieši ir izpausmes. Un izrādās, ka veseliem kokiem tāda relatīvi īslaicīga applūšana vai pārmitra augsne netraucē un nav jau tā, ka ļoti plašas mežu teritorijas bijušas ilgstoši zem ūdens. Cieš šadā gadījumā jau neveseli koki, kuriem ir grūtības pielāgoties jebkādiem apstākļiem, kas nav ideāli, grūtības cīnīties pret jebkādu mazāko traucēki – slimību, kaitēkli vai nepiemērotiem la
-
Koku pārziemošanas stratēģijas
26/08/2025 Duración: 22minTuvojas rudens, kad krāsosies lapas un pēc pāris mēnešiem koki jau būs kaili. Kā gada griezumā koki gatavojas aukstākajai un sausākajai sezonai gadā? Kā pielāgojas dažādas sugas un kā šīs pārziemošanas stratēģijas varētu mainīties, rudeņiem un ziemām kļūstot siltākiem? To skaidrojam sarunā ar Latvijas Universitātes Medicīnas un dzīvības zinātņu fakultātes Ekoloģijas nodaļas profesoru Ģedertu Ieviņu.
-
Gada vēsturnieks Latvijā, skolotājs Roberts Ķipurs: Mācību gads sāksies labi!
25/08/2025 Duración: 51minPar "Gada vēsturnieku Latvijā 2024" izvēlēts Rīgas Valsts 1. ģimnāzijas un Rīgas Mākslas un mediju tehnikuma vēstures skolotājs, Vēstures un sociālo zinību skolotāju biedrības valdes priekšsēdētājs un Latvijaspieminekli.lv veidotājs Roberts Ķipurs. Šī ir pirmā reize, kad par balvas saņēmēju ir izvēlēts vēsturnieks, kam pamata nodarbošanās ir saistīta ar vēstures izglītību pamatskolā un vidusskolā. Pateicoties Ķipura vadītās Vēstures un sociālo zinību skolotāju biedrības aktīvajam darbam, pērn vidusskolās pēc vairāku gadu pārtraukuma atgriezās vēsture kā atsevišķs mācību priekšmets. Studijā tiekamies ar godalgoto vēsturnieku Robertu Ķipuru un Vēstures izpētes un popularizēšanas biedrības nu jau bijušo vadītāju Andri Tihomirovu.
-
Ķīmisko vielu biomonitorings
21/08/2025 Duración: 47minAizvadītājā gadā Rīgas Stradiņa universitātes Darba drošības un vides veselības institūts aicināja piedalīties biomonitoringa pētījumā, lai noskaidrotu ķīmisko vielu iedarbību uz cilvēkiem un ar to saistītos veselības riskus. Iegūti pirmie rezultāti lauka pētījumos, aizvien aktīvi aicināti pieteikties dažādu vecumu grupu iedzīvotāji!